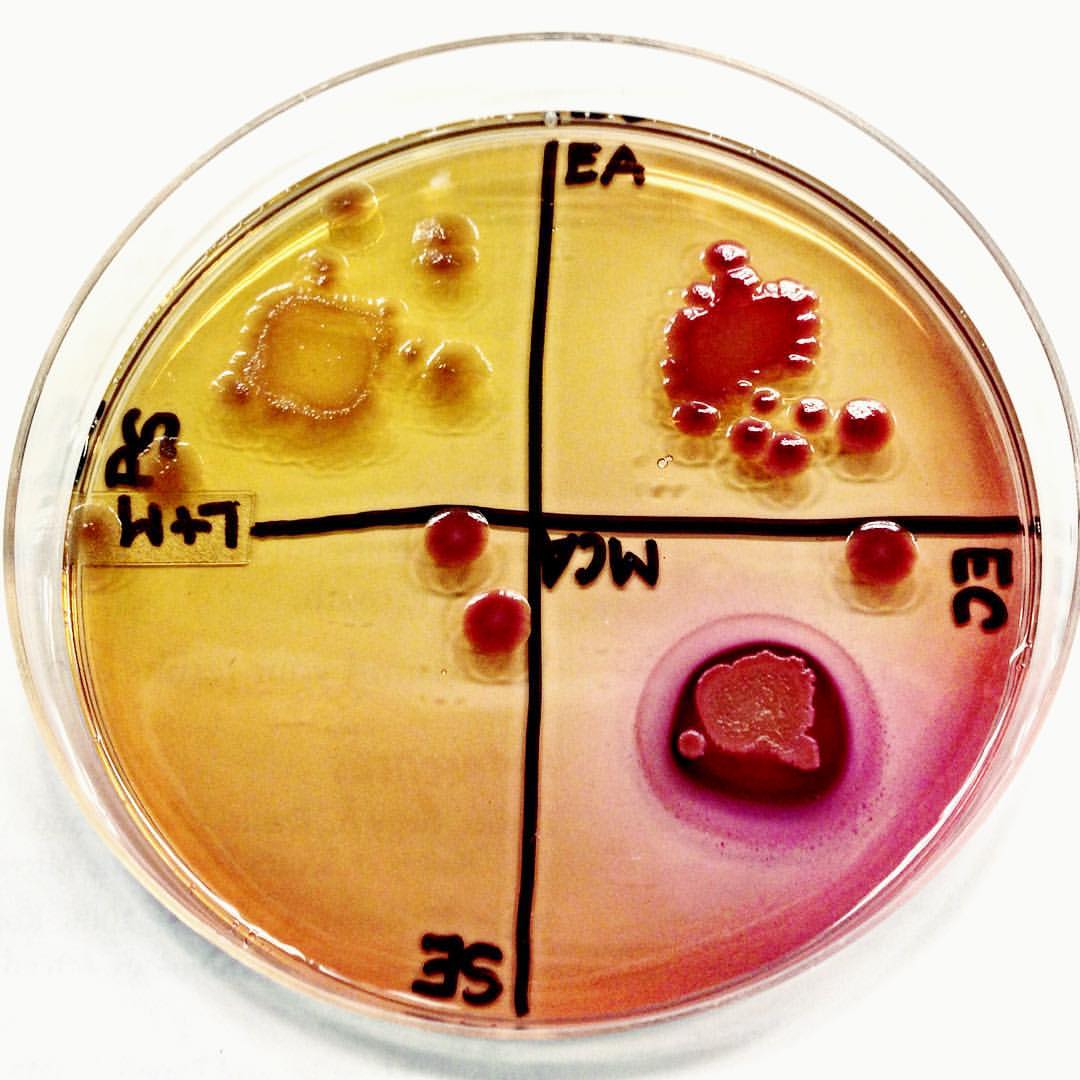

If you haven’t seen Netflix’s Diagnosis by now, you’re definitely missing out! My husband and I started watching it a few months back and we instantly were hooked. For years I have been classified as a medical mystery. So many different doctors told me: “it is in your head” or “it’s just a muscle sprain” and the occasionally “I honestly don’t know what we’re looking at.” I had shingles at seven (rare at that age) which confused a lot of medical personnel, but this was nothing that was to come.
Throughout my childhood I was seemingly healthy. I had chronic nosebleeds most summers, my ankles rolled so many times I lost feeling in them, and my knee caps started dislocating around the age of 12, but other than those issues I was pretty healthy. I had my tonsils and adenoids removed around the age of eight for chronic inflammation and I had ear tubes put in as a baby because of ear infections. Other than being overweight I looked and acted like a normal child.
Dislocations
It started with my ankles. From the time I could first remember I often rolled and twisted my ankles. I had such instability in my ankles that my ankle became numb from how many time I rolled them. Then fast forward to 2003. I did gymnastics and was always super flexible. I was at a K-Mart reaching up for an Easter Basket when I experienced my first knee dislocation. I’ve never experience such pain in my life. Unfortunately many more dislocations in both my knees and hips would follow.
Raynaud’s
Around sixteen my hands and feet started turning blue especially in cold environments or stressful situations. I went to the ER once for “diabetic” like symptoms in my feet (they were blue and numb) and was discharged with a migraine. My primary care physician (PCP) diagnosed me with Raynaud’s Syndrome and I was told to try to limit my extremities to cold temperatures. I bought some special gloves for when the temperature dropped, but we went forward not knowing this was a clue to the puzzle.
Idiopathic Anaphylaxis
Around the age of twenty-two, I started having major issues. It began with an allergy problem. I would have anaphylactic reactions out of now where and to foods I have had multiple times with no problems. I lived in fear as I was terrified that whatever I ate could cause my throat to close. I had one emergency room visit where they administered epinephrine and one allergy clinic emergency where they administered it as well.
I had extensive allergy testing done and thought I had something called mass cell activation disorder. Based upon a blood study the allergy specialist said that I have higher amount of basal cells or the cells that cause a reaction to allergen. I kept Benadryl and my epi-pen on me at all times. Despite testing several allergens, no food could be pin pointed as a trigger and I was thought to be allergic to some unknown spices.
Fast forward a few more years I had a skin and bone marrow biopsy done after I went to see a dermatologist for urticaria and allergic reactions. My skin basically overreacts to stimuli. I was diagnosed with idiopathic anaphylaxis. My bone marrow biopsy came back normal, so they ruled mastocytosis out, yet I am still having allergic reactions. I was told by one doctor that I have irritable bowel syndrome and maybe that was causing these reactions, but since becoming pregnant in January 2018, I have gone into a bit of remission.
Gastrointestinal
I started having gastro problems in 2014 (around 22 years of age). I had chronic diarrhea and a lot of nausea with vomiting. I lost a lot of weight unintentionally because I was so sick that summer. I had a colonoscopy done and all that was reported was inflammation. I am picky about what I eat because I am afraid of the outcome. I started cutting out heavy sugars, fats, and spicy foods. I later went on to have such bad abdominal cramping that it caused me to almost faint. I had my gallbladder taken out at seventeen from rapid weight loss and from cutting out fats from my diet that caused gallstones, so I knew it wasn’t a gallbladder issue. My PCP prescribed dicyclomine for stomach cramping and diagnosed me with what he though was irritable bowel syndrome. Another doctor I saw said he thought I had diverticulitis because of the extreme pain I was in. I remember driving to the hospital and then changing my mind and pulling over to ride the pain.
Atrial Fibrillation
While I was ongoing my allergy and gastrointestinal issues in fall of 2014, I stood up and immediately felt faint. I went to the bathroom and I looked white as a sheet. I felt clammy and my heart felt like it was palpitating out of control.
I had previous “attacks” where my heart would beat so fast for no reason. I went to the hospital once when I was sixteen for it and they ruled it as an anxiety attack, although I disagreed at the time. I know anxiety and I was watching a movie in a hotel room complete relaxed at the time.
I felt beyond sick. I collapsed to the ground and told my boyfriend at the time I needed to go the emergency room. I felt like I might die. I began feeling nauseated and I knew it was serious. Upon arriving I told them I was having chest problems. I thought maybe it was a heart attack. I was already crying because I could feel my heart. It pounded. It felt like it would explode. They did an EKG right away and called the cardiologist on call. They said it was atrial fibrillation. The doctor had never seen someone my age with it. They tried administering drugs to get my heart back in rhythm but to no avail. I consulted with my dad (a nurse) and we agreed I had to be cardioverted back. Basically my heart need to be shocked. They put me to sleep with an anesthetic and I woke up not long after with a pain in my chest but a normal heartbeat.
I had a couple more episodes after this one but no where as severe. I was tested for POTS because of the problems I had feeling faint upon standing and I had almost passed out several time while using the toilet. Despite matching on a lot of the symptoms the test came back negative.
Muscle Pain & Weakness
This has been the most persistent symptom of them all. I have pain every day in my back and neck. I thought when I had my operation (posterior fossa decompression) that I would be better, but it’s much worse. It started in the summer of 2015. My neck and back would put me in tears it hurt so bad. My PCP at the time told me it was a muscle sprain. I tried muscle relaxers to no improvement. Doctor after doctor told me the same thing. Must be a sprain. I finally received a MRI and my doctor failed to mention that the results stated I had a cerebellar tonsil herniation. She told me that it shouldn’t affect me and basically it’s all in my head, so I fired her immediately and went to a neurosurgeon that specialized in Chiari Malformation (after doing extensive research about what cerebellar tonsil herniation meant). Combined with the other symptoms I will further talk about in this post, with the herniated tonsils was too much to “be in my head.” I continue to have major cervical instability pain that makes everyday a challenge for me, but I have great days and I have bad days and keep progressing to hopefully a manageable pain future.
Memory Loss
In that summer of 2015 I began having severe short term memory loss. I used to have such an amazing memory and was quick to recall facts, names, etc., but now I was constantly arguing with my boyfriend at the time about things I didn’t remember. Where did I put my keys? Did I take my medicine? I couldn’t remember doing the most basic of tasks. It was terrifying. How would you feel if you couldn’t remember a good portion of your actions? I started having panic attacks because of what was happening.
Slurred Speech & Aphasia
In addition to the memory issues, my speech began to slur. I wasn’t even aware of the issue until I called my dad and he asked if I was intoxicated. I began to have difficulty speaking my thoughts. A sort of aphasia, I guess you could call it. I often confused words or had a difficult struggle in getting out my thoughts. Going from a scholar to this was extremely defeating. I was in what was supposed to be my senior year of college when this hit. It took a toll on my grades and my self-esteem. I was terrified. As we were formulating ideas (before the Chiari results of the MRI), we were thinking possible brain tumor. Was this the beginning of the end for me? I began to mourn the person I once was. I went from running 5Ks for fun to being a lifeless shell of my former self.
Migraines
The migraine were extreme. I’m talking full on nausea, ocular issues, light sensitivity. I basically lied in a dark room praying for it to end. I couldn’t open my eyes. The pain shot throughout my head and felt as if it were going to explode. I began to see a neurologist. I tried several anti-migraine medications: zomig, amitriptyline, rizatriptan, and others. The migraine were almost daily. I would have to miss class and basically laid there in agony. Too sick to eat, in too much pain to move. I currently am going through a remission of this symptom ever since getting pregnant with my son. It’s been a miracle from suffering so frequently to having them so rarely and I hope it’s something that will continue this trend.
Balance
My balance was beginning to become terrifying. I would suddenly feel as if I would fall over when walking normally. I was on high alert as I was afraid I may fall at any moment. It got to be so bad I’d use a walker to make sure I didn’t fall right before my surgery. I felt like this was an all time low in my health. Here I was. I was supposed to be a healthy, happy twenty-three-year-old and I was using a walker to get to my college classes. I was humiliated, but more so terrified for what was to come.
Nystagmus
Another symptom that appeared mysteriously was found at my eye exam. I ended up having vertical nystagmus that had previously not been seen. I later found out that it was a symptom of Chiari Malformation that had not been caught before. It was very slight, but sure enough my eyes made uncontrolled repetitive movements up and down. Nystagmus can indicate central nervous disease, so I was on high alert after I was told I had it.
With all of these symptoms coming in different waves, I knew it was time. I needed answers. I am tired; tired of the doctors juggling different diagnoses and medicines back and forth. It’s physically and mentally exhausting having to explain myself over and over and people not understanding half of what I go through; Not understanding why I can’t make it to their event and why it’s hard for me to confirm plans and how hard it is for me to put on a mask, pretending everything is okay. I’m tired of answering “I’m fine” or “I’m okay” because explaining that my chronic illness is eating away at me everyday is too long and difficult to mention. I’m tired guys.
I decided to email the doctor from Diagnosis and she led me to the online Facebook support group that aims at trying to diagnose you. And… I got my answer. All this time of not knowing and I’m fairly certain it’s correct and I mean that I am 90% certain. Ehler’s Danlos Syndrome (EDS) with Mast Cell Activation Disorder and Chiari Malformation, both side conditions of EDS. In the past I thought I might have this, but I was told there was no test for it and that is incorrect. I have all of the matching identifiers of this connective tissue disorder.

I couldn’t believe it. I had heard about EDS being in the spoonie community, but I had never really pinpointed it as the cause of my many issues. I took the Beighton Scale Test and I am a 8/9! I am making an appointment soon with a geneticist to have a blood test done and to determine what the odds would be of carrying on my Hypermobile EDS on to my son and future children. I can’t help, but feel comforted that I have a label now. Maybe the doctors will finally take my pain seriously with this diagnosis.
My future is uncertain, but I strive to be one thing: happy.
Here’s to 2020; the year of knowing.
Happy New Year.
xoxo, Cass